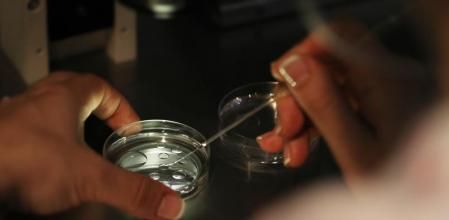
Horizontal

La incertidumbre provocada por la actual pandemia del coronavirus ha impulsado muchos tratamientos de fecundación in vitro (FIV) para conservar la fertilidad. En unos casos acelerando los tratamientos y la implantación de embriones “libres de virus” en fresco y, en otros, optando por su congelación para realizar una transferencia diferida cuando las circunstancias sanitarias, económicas o sociales se juzguen más favorables.
Algunas personas se vieron abocadas directamente a esta congelación de embriones en espera de que cambien las condiciones debido a la interrupción de los tratamientos de reproducción asistida por el confinamiento y la crisis sanitaria derivada de la Covid-19, sin que muchas tuvieran muy claro cómo podía afectar eso después a las probabilidades de éxito del proceso, a las opciones de lograr un embarazo.
La pandemia ha impulsado tratamientos de fecundación in vitro y la posterior congelación de embriones
Ahora, un estudio realizado con 460 mujeres en diversos hospitales y centros de reproducción asistida, públicos y privados, de Dinamarca, Suecia y España –publicado en The British Medical Journal–, arroja luz sobre el tema. De sus datos se desprende que congelar los embriones e implantarlos en diferido no afecta al éxito de los tratamientos de reproducción asistida y ofrece una tasa de embarazo equiparable a los tratamientos que se realizan “en fresco”.
Según los investigadores –entre los que se incluye Nikolaos Polyzos, jefe de Medicina de la Reproducción de Dexeus Mujer–, el número de embarazos conseguidos por fecundación in vitro con embriones en fresco y congelados es equiparable, y tampoco se observan diferencias significativas en el número de niños nacidos finalmente, o en la aparición de complicaciones durante el embarazo, el parto o neonatales.
La conclusión del estudio
Congelar los embriones e implantarlos en diferido no afecta al éxito del tratamiento de reproducción asistida
En concreto, el estudio indica que la tasa de embarazo fue del 27,8% en el grupo de mujeres en el que se habían vitrificado todos los embriones tras la estimulación ovárica y la fecundación en laboratorio, y después se implantó uno de esos embriones previamente descongelado. En el grupo en que se siguió una fecundación in vitro convencional, transfiriendo un único embrión en fresco, el porcentaje de embarazos fue del 29,6%. Y la tasa de nacimientos ascendió al 27,4% y el 28,7%, respectivamente, según los datos difundidos por los autores.
En cuanto al riesgo de complicaciones, los investigadores indican que tampoco se observan diferencias, aunque sí han apreciado un ligero mayor peso de los bebés al nacer y una mayor duración de la gestación en el grupo en que se apostó por congelar los embriones, frente a un mayor riesgo de nacimiento prematuro en el grupo que hizo el tratamiento en fresco.
La tasa de embarazo fue del 27,8% en el grupo con embriones vitrificados y del 29,6% en el grupo con embriones en fresco
Los autores aseguran que los resultados de este trabajo son muy relevantes en la situación actual de pandemia por el coronavirus, porque demuestran que la decisión de congelar embriones a la que se han visto obligadas algunas mujeres por miedo al coronavirus, por el confinamiento o a la interrupción de algunos tratamientos, no merma las posibilidades de éxito cuando usen ese material y se implante el embrión en diferido. “Hasta ahora sólo existían algunos trabajos al respecto en China y Vietnam o minoritarios en Estados Unidos, pero no se había realizado ningún estudio amplio multicéntrico en Europa”, enfatizan.
En los últimos años la práctica de transferir embriones previamente congelados en tratamientos de reproducción asistida ha ido creciendo de forma progresiva gracias a las mejoras introducidas en el laboratorio, como la vitrificación (un proceso que permite congelar material biológico de forma mucho más rápida y segura) y la optimización de los cultivos que facilitan el desarrollo del embrión en el incubador, explican fuentes de Dexeus Mujer, centro que logró el nacimiento del primer bebé español procedente de un embrión previamente congelado, en 1987.
Los investigadores aprecian una gestación más larga con embrión congelado, y más nacimiento prematuro en los frescos
Inicialmente los embriones congelados se plantean como estrategia para reducir el riesgo de desarrollar el síndrome de hiperestimulación ovárica en mujeres con una alta respuesta o con ovarios poliquísticos, y ante la posibilidad de que los niveles elevados de algunas hormonas–como el estradiol o la progesterona– que se registran tras los tratamientos de estimulación ovárica reduzcan la receptividad del útero de cara a la implantación del embrión.
La práctica de transferir embriones congelados se ha visto impulsada por avances en procesos como la vitrificación
Pero si la estrategia de vitrificar todos los embriones obtenidos puede ofrecer los mismos resultados y niveles de éxito que en fresco, los autores del estudio apuntan que quizá esta estrategia sea aplicable de forma general a los pacientes en que esté indicada una fecundación in vitro.